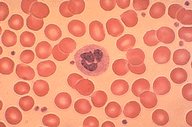

Description
Low-oil magnification view of a normal peripheral
blood smear. The red blood cells are normocytic
with a good hemoglobin content. A normal
segmented neutrophil is in the center of the field.
A normal platelet is immediately adjacent. Other
normal platelets are seen scattered throughout
the field.
|
|
Click on this image
to enlarge it, then
on Back botton
in the Netscape Menu
to shrink it back down


|